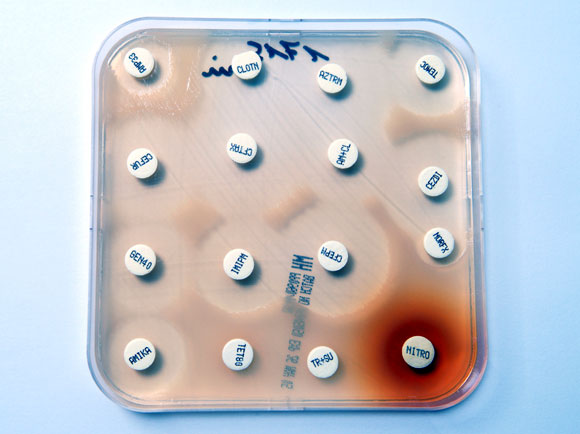
עמידות במהירות שיא, כנראה בגלל מינון נמוך. בדיקת עמידות לאנטיביוטיקות שונות | צילום: Science Photo Library

מאז שנכנסו לשימוש נרחב בשנות ה-40 של המאה הקודמת, תרופות אנטיביוטיות הצילו את חייהם של מיליוני בני אדם. אך עד מהרה התברר שלא מדובר בפתרון קסם, שכן ככל שגבר השימוש בהן כך עלתה גם תפוצתם של חיידקים עמידים לאנטיביוטיקה. כעת הם מאיימים להחזיר לאחור חלק מההישגים הגדולים של הרפואה ולאפשר התפרצות מחודשת של מחלות שהצלחנו כבר לרסן.
חיידקים עמידים הם חיידקים שפיתחו שינויים אקראיים (מוטציות) בחלבונים שהאנטיביוטיקה זקוקה להם כדי להשמיד את החיידקים, ולכן היא אינה יכולה להיקשר אליהם ולפעול כראוי. העמידות מתפתחת לרוב בתהליך אבולוציוני: חיידקים בעלי מוטציה, או צירוף מוטציות, שמקנה להם יתרון מול התרופה האנטיביוטית ישרדו ויתרבו, בשעה שחבריהם שאינם עמידים לתרופה – ימותו. חיידקים עמידים לאנטיביוטיקה הפכו כיום לאחד האתגרים המשמעותיים הניצבים בפני הרפואה.
עמידות יכולה להתפתח בקרב חיידקים במהירות רבה, כפי שהראה למשל מחקר ישראלי, וכעת מחקר חדש, שהתפרסם בכתב העת Antimicrobial Agents and Chemotherapy ממחיש עד כמה התהליך יכול להיות מהיר ודינמי. המחקר עקב אחרי ילד שנדבק בחיידק פסאודומונס אאוריגינוזה (Pseudomonas aeruginosa), שעמיד לרוב התרופות הקיימות. חיידק הפסאודומונס מרבה לפגוע באנשים מדוכאי מערכת חיסון ובמאושפזים בבתי חולים, ואחראי בין השאר לזיהומים במערכת השתן והנשימה ולזיהומים של פצעים וכוויות.
כדי לטפל בזיהום, שהתפשט לזרם הדם, קיבל המטופל תרופה בשם זֶרְבָּקְסַה (Ceftolozane tazobactam), המורכבת משילוב של שתי אנטיביוטיקות. אחת פוגעת בדופן הקשיחה של תא החיידק והשנייה מעכבת את פעילותו של אנזים שמסייע לחיידק לפרק חומרים אנטיביוטיים המסכנים אותו.
עמידות במהירות שיא, כנראה בגלל מינון נמוך. בדיקת עמידות לאנטיביוטיקות שונות | צילום: Science Photo Library
עמידות בהילוך מהיר
בהמשך בחנו החוקרים את רצף ה-DNA של החיידקים שנאספו מהחולה ומצאו שלכל הזנים העמידים היתה מוטציה יחידה בגֵן שאחראי על הייצור של חלבון בשם צפלוספורינאז (Cephalosporinase). השינוי הנקודתי הזה העניק לחיידקים את העמידות לאנטיביוטיקה. מוטציה דומה התגלתה בשנת 2017 בחיידק פסאודומונס עמיד שבודד מחולה לאחר 42 ימי טיפול בתרופה.
החוקרים משערים שטיפול ממושך בזֶרְבָּקְסַה עלול להוביל להתפתחות מהירה של עמידות, אך מסייגים שבמקרה הנוכחי המטופל קיבל מינון נמוך מהמקובל, שכן מדובר בפעוט. לפיכך, ייתכן שהעמידות התפתחה במהירות יוצאת דופן מאחר שמינון התרופה לא היה גבוה מספיק כדי לחסל את כל החיידקים וסיפק לחלקם די זמן לפתח עמידות. למרבה המזל, הזן העמיד לזֶרְבָּקְסַה נמצא רגיש לתרופה אנטיביוטית אחרת.

הכפילו את שיעור החיידקים העמידים. חיידקי הליקובקטר במיקרוסקופ אלקטרונים | מקור: Science Photo Library
סכנה ושמה חיידקים עמידים
ממצאי המחקר הנוכחי מדאיגים גם לאור מחקר שהוצג בכנס האירופי של רופאי מערכת העיכול, בברצלונה (United European Gastroenterology). המחקר בחן את שכיחות העמידות לאנטיביוטיקה אצל חיידקי הליקובקטר פילורי (H. Pylori), שפוגעים בקיבה ועלול לגרום לכיב קיבה (אולקוס), לימפומה וסרטן הקיבה. הטיפול בהליקובקטר כולל שילוב של שלוש אנטיביוטיקות שונות: קלריתרומיצין, אמוקסיצילין וטינידזול. שיעורי ההצלחה של הטיפול המשולב גבוהים ועומדים על כ-90 אחוז.
עם זאת מידע שנאסף מ-1,232 חולים בהליקובקטר מ-18 מדינות ברחבי אירופה העלה נתונים מדאיגים. החוקרים מצאו כי שיעורים של חיידקי ההליקובקטר העמיד לקלריתרומיצין עמד בשנת 1998 על כ-9.9 אחוזים מכלל החולים, וזינק מאז פי יותר משניים, ל-21.6 אחוז. החוקרים מציינים כי שיעור החולים שנדבקו בחיידקים עמידים היה גבוה במיוחד בדרום איטליה (39.9 אחוז), קרואטיה (34.6 אחוז) ויוון (30 אחוז), מדינות שמתאפיינות בשימוש יתר באנטיביוטיקה ושאין בהן תמיכה ממשלתית בתוכניות לצמצום שיעור העמידויות.
מוביל המחקר, פרנסיס מֶגְרוֹ (Megraud), ציין כי ''כבר כעת זיהומי ההליקובטר קשים לטיפול ומחייבים טיפול משולב. נראה כי ככל שיחלוף הזמן אפשרויות הטיפול בחיידק ילכו ויצמצמו, ואפילו יאבדו את יעילותן אם לא יימצאו שיטות טיפול נוספות. הירידה ביעילות הטיפול עלולה להוביל לעלייה בשכיחות הסיבוכים, כמו כיב קיבה וסרטן הקיבה''.